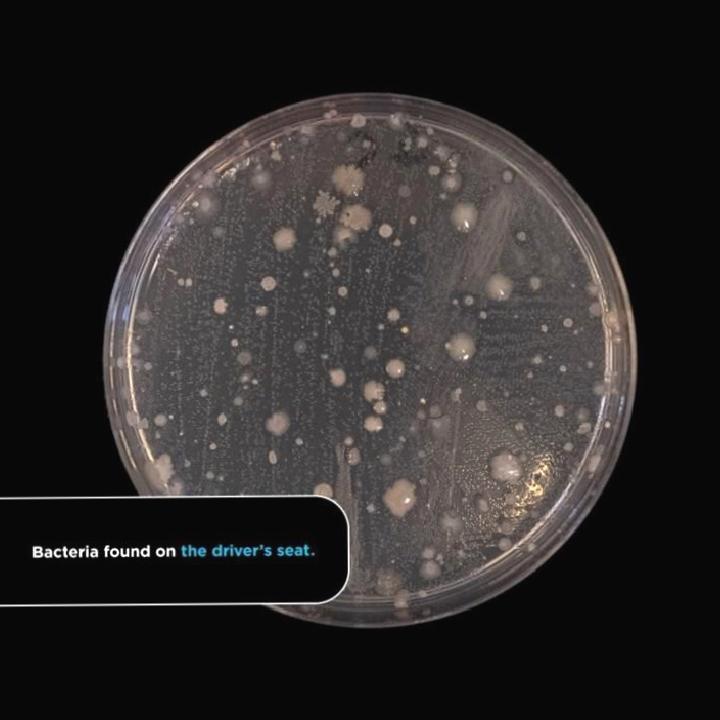

Yapılan yeni bir araştırmaya nazaran ortalama bir araç kabininin tuvaletlerden daha fazla bakteri barındırdığı belirlenmiş. En fazla …


Yapılan yeni bir araştırmaya nazaran ortalama bir araç kabininin tuvaletlerden daha fazla bakteri barındırdığı belirlenmiş. En fazla bakterinin görüldüğü alan ise bagaj olmuş.
Scrap Car Comparison tarafından yapılan araştırmada, Aston Üniversitesi Biyolojik Bilimler Okulu’ndaki araştırmacılar vazife aldı. Bu kapsamda halka açık iki tuvaletten ve beş farklı aracın çeşitli yerlerinden örnekler toplandı. Bu araçlardan kimileri eski olmakla birlikte bir tanesi yalnızca iki yaşındaydı.
Araştırmaya mevzu olan araçlarda dışkı bakterileri bulundu. Üstte söylediğimiz üzere en fazla bakterinin bulunduğu alan da bagaj kısmı oldu. Market alışverişi yaptığımızda, aldığımız yiyecekleri genelde bagaja koyuyoruz. Anlaşılan o ki bu alanın paklığına daha fazla kıymet vermek gerekiyor.
Araç içerisindeki en kirli alanlar sırasıyla şöyle:
Üstteki sonuçlara nazaran araç içerisindeki en pak yerlerden biri direksiyon simidi. Bu epeyce enteresan zira en sık temas edilen yerlerden biri olduğu için en kirli noktalardan biri olduğu düşünülür. Öte yandan araştırmacılar, bunun nedenini pandemi nedeniyle dezenfektan vb. şeyler kullanıyor olmamıza bağlıyor.
Araştırmaya bahis olan bakteriler bizi direkt hasta edecek kadar tehlikeli değil. Bilhassa sık sık ellerini yıkayanlar için. Lakin araştırmacılar, “kir yalnızca bizim gördüğümüz kadarıyla sonlu değildir” diyor ve araç sahiplerinin paklığa daha fazla ehemmiyet göstermesinin hastalanma riskini de azaltacağını hatırlatıyor.
Pekala siz aracınızın paklığı için neler yapıyorsunuz?